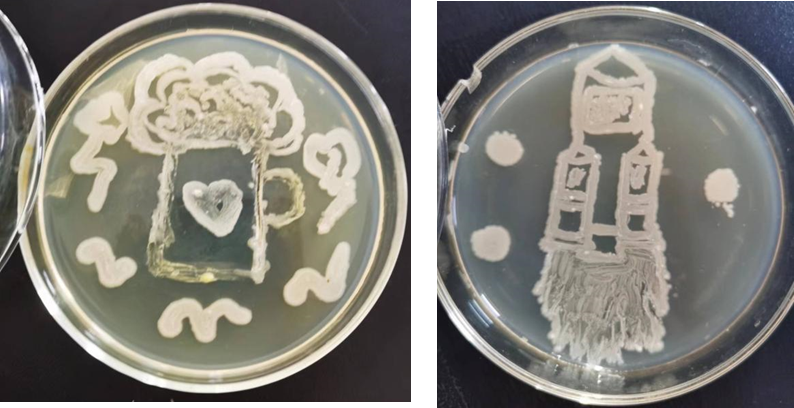
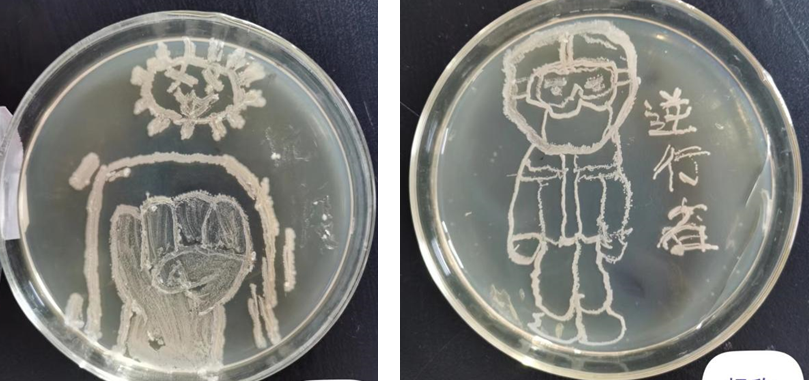

为深入学习宣传贯彻党的二十大精神,w优德88中文版借助《食品微生物》课程,在22级食品营养与检验(3+2),22级食品生物技术(3+2), 22级食品营养与检验三个班级,开展“青春献礼二十大,皿上献“画””主题实训教学活动。
在王红燕教师的精心指导下,员工用所学知识,以培养皿为画布,微生物为“颜料”,生动勾勒了一幅幅精美作品,抒发自己的家国情怀。
这些图片和文字是培养皿上长出的微生物,需要菌种分离、培养基制备、超净台上接种、恒温培养等一系列流程,这些作品也是生科学子对党的深情告白。
此次实训教学活动,是《食品微生物》课程思政内容的一部分,是在让员工学习专业知识的同时,用党的科学理论武装青年,用党的初心使命感召青年,真正将党的二十大精神走进课堂,走深走实,入脑入心。
部分图片如下:

祖国 欢庆

党 二十大
团结杯 问星一号
阻击疫情 你我同行

生科 爱国
图片作者:从上到下,从左到右,10幅图的作者分别是:苏玲玲、马梦雪、苏玲玲、仝文慧、徐文杰、李莉、燕玲、杨欣、张佳兴、仇光贤